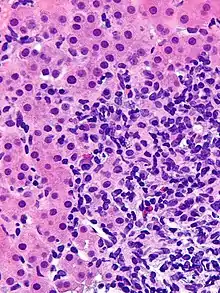

| Autoimmune hepatitis | |
|---|---|
![]() | |
| Micrograph showing a lymphoplasmacytic interface hepatitis—the characteristic histomorphologic finding of autoimmune hepatitis. Liver biopsy. H&E stain. | |
| Specialty | Gastroenterology, hepatology |
| Symptoms | Often asymptomatic, fatigue, right upper abdominal pain, anorexia, nausea, jaundice, joint pain, rash |
| Complications | Chronic liver disease, cirrhosis |
| Usual onset | Bimodal presentation: 10-20 years of age, 40-50 years of age |
| Duration | Lifelong |
| Types | Type 1, type 2, seronegative |
| Causes | Genetic predisposition with environmental trigger |
| Risk factors | Female gender, additional autoimmune disease |
| Diagnostic method | Liver enzyme levels, antibody panels. Definitive: Liver biopsy |
| Differential diagnosis | Primary biliary cholangitis Primary sclerosing cholangitis |
| Treatment | Prednisone, Azathioprine |
| Prognosis | <50% survival if untreated, >90% survival if treated |
| Frequency | Incidence 1-2 per 100,000 per year Prevalence 10-25 per 100,000 |
Autoimmune hepatitis, formerly known as lupoid hepatitis, plasma cell hepatitis, or autoimmune chronic active hepatitis, is a chronic, autoimmune disease of the liver that occurs when the body's immune system attacks liver cells, causing the liver to be inflamed. Common initial symptoms may include fatigue, nausea, muscle aches, or weight loss or signs of acute liver inflammation including fever, jaundice, and right upper quadrant abdominal pain. Individuals with autoimmune hepatitis often have no initial symptoms and the disease may be detected by abnormal liver function tests and increased protein levels during routine bloodwork or the observation of an abnormal-looking liver during abdominal surgery.[1]
Anomalous presentation of MHC class II receptors on the surface of liver cells,[2] possibly due to genetic predisposition or acute liver infection, causes a cell-mediated immune response against the body's own liver, resulting in autoimmune hepatitis. This abnormal immune response results in inflammation of the liver, which can lead to further symptoms and complications such as fatigue and cirrhosis.[3] The disease is most often diagnosed in patients in their late teens or early 20s and between the ages of 40 and 50. It affects women more commonly than men.[4]
Signs and symptoms
Autoimmune hepatitis may present completely asymptomatic (12–35% of the cases), with signs of chronic liver disease, or acute or even fulminant hepatic failure.[5][6]
People usually present with one or more nonspecific, long-lasting symptoms such as fatigue, general ill health, lethargy, weight loss, mild right upper quadrant abdominal pain, malaise, anorexia, itching, nausea, jaundice or joint pain especially affecting the small joints. Rarely, rash or unexplained fever may appear. In women, the absence of menstruation (amenorrhoea) is a frequent feature. Physical examination may be normal, but it may also reveal signs and symptoms of chronic liver disease. Many people have only laboratory abnormalities as their initial presentation, as unexplained increase in transaminases and are diagnosed during an evaluation for other reasons. Others have already developed cirrhosis at diagnosis.[6] Of note, alkaline phosphatase and bilirubin are usually normal.
Autoimmune hepatitis may overlap with other autoimmune conditions, mainly type 1 diabetes mellitus, ulcerative colitis, lupus, celiac disease, vasculitis, and autoimmune thyroiditis.[5]
Cause
The prevailing theory for the development of autoimmune hepatitis is thought to be the interplay of genetic predisposition, an environmental trigger (virus, drugs, herbs, immunizations), and failure of the native immune system resulting in chronic inflammation of hepatocytes and subsequent fibrosis of the liver.[7][8][9]
There is no specific evidence of the cause. Sixty percent of patients have findings associated with chronic hepatitis but without serologic evidence of a viral infection. The disease is strongly associated with anti-smooth muscle autoantibodies.[10]
The exact genes and triggers responsible remain undefined, but studies show association of early-onset, severe disease with the HLA-DR3 serotype and late-onset disease with the HLA-DR4 serotype.[11]
Diagnosis
The diagnosis of autoimmune hepatitis is best achieved with a combination of clinical, laboratory, and histological findings after excluding other etiological factors (e.g. viral, hereditary, metabolic, cholestatic, and drug-induced liver diseases). The requirement for histological examination necessitates a liver biopsy, typically performed with a needle by the percutaneous route, to provide liver tissue.
Autoantibodies
A number of specific antibodies found in the blood (antinuclear antibody (ANA), anti-smooth muscle antibody (SMA), anti-liver kidney microsomal antibodies (LKM-1, LKM-2, LKM-3), anti soluble liver antigen (SLA), liver–pancreas antigen (LP), and anti-mitochondrial antibody (AMA)) are of use, as is finding an increased immunoglobulin G level. The presence of anti-mitochondrial antibody is more suggestive of primary biliary cholangitis. Hypergammaglobulinemia is also of diagnostic value.[12]
Histology
Autoimmune hepatitis can be characterized histologically by the following nonspecific findings:[13][14][15][16]
- Portal mononuclear cell infiltrate that invades the boundary surrounding the portal triad and infiltrates the surrounding lobule.
- Periportal lesions, also known as interface hepatitis, that spare the biliary tree (may include centrizonal necrosis).
- Bile duct abnormalities (cholangitis, ductal injury, ductular reaction) can be seen and should prompt evaluation for primary biliary cholangitis or sarcoidosis if granulomas are observed.
- Plasma cell infiltrate, rosettes of hepatocytes, and multinucleated giant cells.
- Varying degrees of fibrosis (except in the mildest form of autoimmune hepatitis). Bridging fibrosis that connects the portal and central areas can distort the structure of the hepatic lobule and result in cirrhosis.
Diagnostic scoring
The Internal Autoimmune Hepatitis Group developed a standardized scoring system for clinical diagnosis in population studies but lacks value in individualized cases.[17] A simplified scoring system for clinical use incorporates titers of autoantibodies, total IgG levels, liver histology, and the exclusion of viral hepatitis for diagnostic scoring.[18]
Classification
On the basis of detected autoantibodies, autoimmune hepatitis can be classified into three subtypes but have no distinct clinical presentations.
- Type 1 autoimmune hepatitis. Positive antibodies include:[19][20]
- Antinuclear antibody (ANA)
- Anti-smooth muscle antibody (ASMA) - 65% of people
- Anti-actin antibodies
- Anti-mitochondrial antibodies - rare except for overlap syndromes with primary biliary cholangitis
- Anti-soluble liver antigen/liver pancreas antibody antigen - 20% of people
- Anti-double stranded DNA - 30% of people
- Atypical perinuclear anti-neutrophil cytoplasmic antibodies (p-ANCA)
- Type 2 autoimmune hepatitis. Positive antibodies include:[21]
- Liver Kidney Microsomal antibody (LKM-1)
- Anti-liver cytosol antibody-1 (SLC-1)
- Autoantibody negative autoimmune hepatitis.[22]
- Lack positive ANA, ASMA, LKM-1, etc. antibody panels but present with clinical features of autoimmune hepatitis that resolve with standard treatment.
Differential diagnosis
Other diagnoses to consider include conditions that may cause acute hepatitis or chronic liver inflammation that may be accompanied by cirrhosis:
- Other autoimmune diseases that involve the liver:
- Primary biliary cholangitis - the presence of isolated elevated AMA antibodies usually signifies primary biliary cholangitis rather than autoimmune hepatitis and further diagnostic evaluation is needed.[23][24]
- Overlap syndromes - autoimmune hepatitis may present similarly to primary sclerosing cholangitis but people with primary sclerosing cholangitis have stricturing and dilatation of intra/extra-hepatic ducts while people with autoimmune hepatitis generally have a spared biliary tree.[23]
- Other causes of hepatitis:
- Viral hepatitis - it is necessary to distinguish autoimmune hepatitis from acute hepatitis caused by Hepatitis A/B/C/D/E, herpes simplex, varicella zoster, EBV, CMV virus
- Drug-induced liver injury - portal neutrophils are more prevalent in drug-induced liver injury on liver biopsy and can help distinguish the two
- Nonalcoholic steatohepatitis - related medical history and liver biopsy showing fatty infiltration and the presence of neutrophils and central fibrosis can distinguish the two
- Lupus-associated liver disease - rarely presents with elevated ASMA or AMA antibodies
- Acute liver failure - people with acute liver failure may have elevated autoantibodies but the antibodies alone are not enough for the diagnosis of autoimmune hepatitis
- Iron overload - elevated iron in the body can cause liver inflammation
Treatment
The choice for medical treatment should be based on the individual's severity of symptoms, quantitative elevation of liver enzymes and antibody levels, findings on liver biopsy, and ability to tolerate side effects of medical therapy.
Generally, treatment is not required in asymptomatic patients with normal liver enzyme and antibody levels and liver biopsies that do not demonstrate inflammation because these patients are at a low risk of disease progression. In symptomatic individuals with evidence of interface hepatitis and necrosis on liver biopsy, it is recommended to offer treatment especially if the patient is young and can tolerate the side effects of medical therapy.[25][26]
The mainstay of treatment involves the use of immunosuppressive glucocorticoids such as prednisone during acute episodes and resolution of symptoms can be achieved in up to 60–80% of cases, although many will eventually experience a relapse.[27] In individuals with moderate to severe disease who may not tolerate glucocorticoids, lower dose prednisone monotherapy or combination with azathioprine is a reasonable alternative. Budesonide has been shown to be more effective in inducing remission than prednisone, but evidence is scarce and more data is needed before it can be routinely recommended.[28] Those with autoimmune hepatitis who do not respond to glucocorticoids and azathioprine may be given other immunosuppressives like mycophenolate, ciclosporin, tacrolimus, or methotrexate.[27][29][30][31]
Liver cirrhosis can develop in about 7% to 40% of treated patients. People with the highest risk for progression to cirrhosis are those with incomplete response to treatment, treatment failure, and multiple relapses. Once cirrhosis develops, management of liver cirrhosis in autoimmune hepatitis is standard regardless of etiology. Liver transplantation is the standard of care in people presenting with fulminant liver failure or those with the progression of disease despite multiple lines of therapy.[32][33][34]
Prognosis
Without treatment, the ten-year survival rate for individuals with symptomatic autoimmune hepatitis is 50%. However, with treatment, the ten-year survival rate is above 90%. Despite the benefits of treatment, people with autoimmune hepatitis generally have a lower transplant-free survival than the general population.[35][36][37] Outcomes with liver transplant are generally favorable with a five-year survival greater than 80 percent.[4]
Presentation and response to therapy may differ according to race. African Americans appear to present with a more aggressive disease that is associated with worse outcomes.[38][39]
There has been strong evidence that patients with autoimmune hepatitis can develop mental health disorders like schizophrenia and bipolar disorder later in their life.[40]
Epidemiology
Autoimmune hepatitis can develop in people of any race or age but occurs most frequently in women.[41][42][43] Eighty percent of cases are the type 1 subtype with women being affected 4 times more often than men; for the type 2 subtype, women are affected 10 times more often than men.[44][45]
European studies suggest a disease incidence of 1 to 2 people affected per 100,000 population with a prevalence of 10 to 25 people per 100,000 population.[42][46][47][48]
The disease has a bimodal peak occurring between the ages of 10 and 20 and then later in life between the ages of 40 and 50.[43][48]
History
Autoimmune hepatitis was previously called "lupoid" hepatitis due to people having an associated autoimmune disease like system lupus erythematosus at time of diagnosis, which was believed to be its cause. It was originally described in the early 1950s.[49]
References
- ↑ Czaja AJ (May 2004). "Autoimmune liver disease". Current Opinion in Gastroenterology. 20 (3): 231–240. doi:10.1097/00001574-200405000-00007. PMID 15703647.
- ↑ Franco A, Barnaba V, Natali P, Balsano C, Musca A, Balsano F (May–June 1988). "Expression of class I and class II major histocompatibility complex antigens on human hepatocytes". Hepatology. 8 (3): 449–454. doi:10.1002/hep.1840080302. PMID 2453428. S2CID 23341082.
- ↑ National Digestive Diseases Information Clearinghouse. "Digestive Disease: Autoimmune Hepatitis". Archived from the original on 15 September 2010. Retrieved October 9, 2010.
- 1 2 Manns MP, Czaja AJ, Gorham JD, Krawitt EL, Mieli-Vergani G, Vergani D, Vierling JM (June 2010). "Diagnosis and management of autoimmune hepatitis". Hepatology. 51 (6): 2193–2213. doi:10.1002/hep.23584. PMID 20513004. S2CID 30356212.
- 1 2 Than NN, Jeffery HC, Oo YH (2016). "Autoimmune Hepatitis: Progress from Global Immunosuppression to Personalised Regulatory T Cell Therapy". Canadian Journal of Gastroenterology & Hepatology (Review). 2016: 7181685. doi:10.1155/2016/7181685. PMC 4904688. PMID 27446862.
- 1 2 Zachou K, Muratori P, Koukoulis GK, Granito A, Gatselis N, Fabbri A, et al. (October 2013). "Review article: autoimmune hepatitis -- current management and challenges". Alimentary Pharmacology & Therapeutics (Review). 38 (8): 887–913. doi:10.1111/apt.12470. PMID 24010812. S2CID 29295458.

- ↑ Silva, Juliana; Brito, Beatriz S.; Silva, Isaac Neri de N.; Nóbrega, Viviane G.; da Silva, Maria Carolina S. M.; Gomes, Hemerson Dyego de N.; Fortes, Flora Maria; Pimentel, Andrea M.; Mota, Jaciane; Almeida, Neogélia; Surlo, Valdiana C. (2019). "Frequency of Hepatobiliary Manifestations and Concomitant Liver Disease in Inflammatory Bowel Disease Patients". BioMed Research International. 2019: 7604939. doi:10.1155/2019/7604939. ISSN 2314-6141. PMC 6374878. PMID 30834274.
- ↑ Palle, Sirish K.; Naik, Kushal B.; McCracken, Courtney E.; Kolachala, Vasantha L.; Romero, Rene; Gupta, Nitika A. (May 2019). "Racial disparities in presentation and outcomes of paediatric autoimmune hepatitis". Liver International. 39 (5): 976–984. doi:10.1111/liv.14081. ISSN 1478-3231. PMID 30802337. S2CID 73491226.
- ↑ Agbim, Uchenna; Asrani, Sumeet K. (April 2019). "Non-invasive assessment of liver fibrosis and prognosis: an update on serum and elastography markers". Expert Review of Gastroenterology & Hepatology. 13 (4): 361–374. doi:10.1080/17474124.2019.1579641. ISSN 1747-4132. PMID 30791772. S2CID 73467654.
- ↑ Doycheva, Iliana; Watt, Kymberly D.; Gulamhusein, Aliya F. (June 2019). "Autoimmune hepatitis: Current and future therapeutic options". Liver International. 39 (6): 1002–1013. doi:10.1111/liv.14062. ISSN 1478-3231. PMID 30716203. S2CID 73417414.
- ↑ "Autoimmune hepatitis | Genetic and Rare Diseases Information Center (GARD) – an NCATS Program". rarediseases.info.nih.gov. Retrieved 2018-04-17.
- ↑ Alvarez F, Berg PA, Bianchi FB, Bianchi L, Burroughs AK, Cancado EL, et al. (November 1999). "International Autoimmune Hepatitis Group Report: review of criteria for diagnosis of autoimmune hepatitis". Journal of Hepatology. 31 (5): 929–938. doi:10.1016/S0168-8278(99)80297-9. PMID 10580593.
- ↑ Hofer H, Oesterreicher C, Wrba F, Ferenci P, Penner E (March 2006). "Centrilobular necrosis in autoimmune hepatitis: a histological feature associated with acute clinical presentation". Journal of Clinical Pathology. 59 (3): 246–249. doi:10.1136/jcp.2005.029348. PMC 1860344. PMID 16505273.
- ↑ Verdonk RC, Lozano MF, van den Berg AP, Gouw AS (September 2016). "Bile ductal injury and ductular reaction are frequent phenomena with different significance in autoimmune hepatitis". Liver International. 36 (9): 1362–1369. doi:10.1111/liv.13083. PMID 26849025. S2CID 206174384.
- ↑ Abe M, Onji M, Kawai-Ninomiya K, Michitaka K, Matsuura B, Hiasa Y, Horiike N (February 2007). "Clinicopathologic features of the severe form of acute type 1 autoimmune hepatitis". Clinical Gastroenterology and Hepatology. 5 (2): 255–258. doi:10.1016/j.cgh.2006.10.011. PMID 17218164.
- ↑ Stravitz RT, Lefkowitch JH, Fontana RJ, Gershwin ME, Leung PS, Sterling RK, et al. (February 2011). "Autoimmune acute liver failure: proposed clinical and histological criteria". Hepatology. 53 (2): 517–526. doi:10.1002/hep.24080. PMC 3080034. PMID 21274872.
- ↑ Alvarez F, Berg PA, Bianchi FB, Bianchi L, Burroughs AK, Cancado EL, et al. (November 1999). "International Autoimmune Hepatitis Group Report: review of criteria for diagnosis of autoimmune hepatitis". Journal of Hepatology. 31 (5): 929–938. doi:10.1016/s0168-8278(99)80297-9. PMID 10580593.
- ↑ Hennes EM, Zeniya M, Czaja AJ, Parés A, Dalekos GN, Krawitt EL, et al. (July 2008). "Simplified criteria for the diagnosis of autoimmune hepatitis". Hepatology. 48 (1): 169–176. doi:10.1002/hep.22322. PMID 18537184. S2CID 205865590.
- ↑ Czaja AJ, Morshed SA, Parveen S, Nishioka M (September 1997). "Antibodies to single-stranded and double-stranded DNA in antinuclear antibody-positive type 1-autoimmune hepatitis". Hepatology. 26 (3): 567–572. doi:10.1002/hep.510260306. PMID 9303484. S2CID 24530335.
- ↑ Terjung B, Spengler U, Sauerbruch T, Worman HJ (August 2000). ""Atypical p-ANCA" in IBD and hepatobiliary disorders react with a 50-kilodalton nuclear envelope protein of neutrophils and myeloid cell lines". Gastroenterology. 119 (2): 310–322. doi:10.1053/gast.2000.9366. PMID 10930366.
- ↑ Bridoux-Henno L, Maggiore G, Johanet C, Fabre M, Vajro P, Dommergues JP, et al. (September 2004). "Features and outcome of autoimmune hepatitis type 2 presenting with isolated positivity for anti-liver cytosol antibody". Clinical Gastroenterology and Hepatology. 2 (9): 825–830. doi:10.1016/s1542-3565(04)00354-4. PMID 15354284.
- ↑ Heneghan MA, Yeoman AD, Verma S, Smith AD, Longhi MS (October 2013). "Autoimmune hepatitis". Lancet. 382 (9902): 1433–1444. doi:10.1016/S0140-6736(12)62163-1. PMID 23768844. S2CID 20466113.
- 1 2 Rust, Christian; Beuers, Ulrich (2008-06-07). "Overlap syndromes among autoimmune liver diseases". World Journal of Gastroenterology. 14 (21): 3368–3373. doi:10.3748/wjg.14.3368. ISSN 1007-9327. PMC 2716591. PMID 18528934.
- ↑ Czaja, Albert J. (September 2014). "Cholestatic phenotypes of autoimmune hepatitis". Clinical Gastroenterology and Hepatology. 12 (9): 1430–1438. doi:10.1016/j.cgh.2013.08.039. ISSN 1542-7714. PMID 24013108.
- ↑ Mack, Cara L.; Adams, David; Assis, David N.; Kerkar, Nanda; Manns, Michael P.; Mayo, Marlyn J.; Vierling, John M.; Alsawas, Mouaz; Murad, Mohammad H.; Czaja, Albert J. (August 2020). "Diagnosis and Management of Autoimmune Hepatitis in Adults and Children: 2019 Practice Guidance and Guidelines From the American Association for the Study of Liver Diseases". Hepatology. 72 (2): 671–722. doi:10.1002/hep.31065. ISSN 1527-3350. PMID 31863477. S2CID 209435271.
- ↑ Gleeson, Dermot; Heneghan, Michael A.; British Society of Gastroenterology (December 2011). "British Society of Gastroenterology (BSG) guidelines for management of autoimmune hepatitis". Gut. 60 (12): 1611–1629. doi:10.1136/gut.2010.235259. ISSN 1468-3288. PMID 21757447. S2CID 7823073.
- 1 2 Krawitt EL (January 1994). "Autoimmune hepatitis: classification, heterogeneity, and treatment". The American Journal of Medicine. 96 (1A): 23S–26S. doi:10.1016/0002-9343(94)90186-4. PMID 8109584.
- ↑ Manns MP, Strassburg CP (2011). "Therapeutic strategies for autoimmune hepatitis". Digestive Diseases. 29 (4): 411–415. doi:10.1159/000329805. PMID 21894012. S2CID 42014343.
- ↑ Inductivo-Yu, Ira; Adams, Atoya; Gish, Robert G.; Wakil, Adil; Bzowej, Natalie H.; Frederick, R. Todd; Bonacini, Maurizio (July 2007). "Mycophenolate mofetil in autoimmune hepatitis patients not responsive or intolerant to standard immunosuppressive therapy". Clinical Gastroenterology and Hepatology. 5 (7): 799–802. doi:10.1016/j.cgh.2007.02.030. ISSN 1542-7714. PMID 17509945.
- ↑ Alvarez, F.; Ciocca, M.; Cañero-Velasco, C.; Ramonet, M.; de Davila, M. T.; Cuarterolo, M.; Gonzalez, T.; Jara-Vega, P.; Camarena, C.; Brochu, P.; Drut, R. (February 1999). "Short-term cyclosporine induces a remission of autoimmune hepatitis in children". Journal of Hepatology. 30 (2): 222–227. doi:10.1016/s0168-8278(99)80065-8. ISSN 0168-8278. PMID 10068099.
- ↑ Aqel, Bashar A.; Machicao, Victor; Rosser, Barry; Satyanarayana, Raj; Harnois, Denise M.; Dickson, Rolland C. (October 2004). "Efficacy of tacrolimus in the treatment of steroid refractory autoimmune hepatitis". Journal of Clinical Gastroenterology. 38 (9): 805–809. doi:10.1097/01.mcg.0000139050.67178.be. ISSN 0192-0790. PMID 15365410. S2CID 5887449.
- ↑ Stephen J Mcphee, Maxine A Papadakis. Current medical diagnosis and treatment 2009 page.596
- ↑ Dyson, Jessica K.; De Martin, Eleonora; Dalekos, George N.; Drenth, Joost P. H.; Herkel, Johannes; Hubscher, Stefan G.; Kelly, Deirdre; Lenzi, Marco; Milkiewicz, Piotr; Oo, Ye H.; Heneghan, Michael A. (March 2019). "Review article: unanswered clinical and research questions in autoimmune hepatitis-conclusions of the International Autoimmune Hepatitis Group Research Workshop". Alimentary Pharmacology & Therapeutics. 49 (5): 528–536. doi:10.1111/apt.15111. ISSN 1365-2036. PMID 30671977. S2CID 58949671.
- ↑ Harrison, Laura; Gleeson, Dermot (April 2019). "Stopping immunosuppressive treatment in autoimmune hepatitis (AIH): Is it justified (and in whom and when)?". Liver International. 39 (4): 610–620. doi:10.1111/liv.14051. ISSN 1478-3231. PMID 30667576. S2CID 58613382.
- ↑ Hoeroldt B, McFarlane E, Dube A, Basumani P, Karajeh M, Campbell MJ, Gleeson D (June 2011). "Long-term outcomes of patients with autoimmune hepatitis managed at a nontransplant center". Gastroenterology. 140 (7): 1980–1989. doi:10.1053/j.gastro.2011.02.065. PMID 21396370.
- ↑ Ngu JH, Gearry RB, Frampton CM, Stedman CA (June 2013). "Predictors of poor outcome in patients w ith autoimmune hepatitis: a population-based study". Hepatology. 57 (6): 2399–2406. doi:10.1002/hep.26290. PMID 23359353. S2CID 8890549.
- ↑ Ngu JH, Gearry RB, Frampton CM, Stedman CA (February 2012). "Mortality and the risk of malignancy in autoimmune liver diseases: a population-based study in Canterbury, New Zealand". Hepatology. 55 (2): 522–529. doi:10.1002/hep.24743. PMID 21994151. S2CID 30580281.
- ↑ Lim KN, Casanova RL, Boyer TD, Bruno CJ (December 2001). "Autoimmune hepatitis in African Americans: presenting features and response to therapy". The American Journal of Gastroenterology. 96 (12): 3390–3394. doi:10.1111/j.1572-0241.2001.05272.x. PMID 11774954. S2CID 464912.
- ↑ Verma S, Torbenson M, Thuluvath PJ (December 2007). "The impact of ethnicity on the natural history of autoimmune hepatitis". Hepatology. 46 (6): 1828–1835. doi:10.1002/hep.21884. PMID 17705297. S2CID 12506294.
- ↑ Keerthana Mani Jeyanthi D, Katta MR, Mishra S, Christopher J, Jain A, Jamil M (2021-06-12). "Evaluation of Autoimmune Diseases with Mental Health Disorders: An Original Research". Annals of the Romanian Society for Cell Biology. 25 (6): 10860–10864.
- ↑ Boberg, K. M.; Aadland, E.; Jahnsen, J.; Raknerud, N.; Stiris, M.; Bell, H. (January 1998). "Incidence and prevalence of primary biliary cirrhosis, primary sclerosing cholangitis, and autoimmune hepatitis in a Norwegian population". Scandinavian Journal of Gastroenterology. 33 (1): 99–103. doi:10.1080/00365529850166284. ISSN 0036-5521. PMID 9489916.
- 1 2 Werner, Mårten; Prytz, Hanne; Ohlsson, Bodil; Almer, Sven; Björnsson, Einar; Bergquist, Annika; Wallerstedt, Sven; Sandberg-Gertzén, Hanna; Hultcrantz, Rolf; Sangfelt, Per; Weiland, Ola (2008). "Epidemiology and the initial presentation of autoimmune hepatitis in Sweden: a nationwide study". Scandinavian Journal of Gastroenterology. 43 (10): 1232–1240. doi:10.1080/00365520802130183. ISSN 1502-7708. PMID 18609163. S2CID 205455312.
- 1 2 Al-Chalabi, Thawab; Boccato, Sylvia; Portmann, Bernard C.; McFarlane, Ian G.; Heneghan, Michael A. (October 2006). "Autoimmune hepatitis (AIH) in the elderly: a systematic retrospective analysis of a large group of consecutive patients with definite AIH followed at a tertiary referral centre". Journal of Hepatology. 45 (4): 575–583. doi:10.1016/j.jhep.2006.04.007. ISSN 0168-8278. PMID 16899323.
- ↑ Heneghan, Michael A.; Yeoman, Andrew D.; Verma, Sumita; Smith, Alastair D.; Longhi, Maria Serena (2013-10-26). "Autoimmune hepatitis". Lancet. 382 (9902): 1433–1444. doi:10.1016/S0140-6736(12)62163-1. ISSN 1474-547X. PMID 23768844. S2CID 20466113.
- ↑ Czaja, Albert J.; Donaldson, Peter T. (August 2002). "Gender effects and synergisms with histocompatibility leukocyte antigens in type 1 autoimmune hepatitis". The American Journal of Gastroenterology. 97 (8): 2051–2057. doi:10.1111/j.1572-0241.2002.05921.x. ISSN 0002-9270. PMID 12190176. S2CID 20267837.
- ↑ Ngu, Jing H.; Bechly, Kristen; Chapman, Bruce A.; Burt, Michael J.; Barclay, Murray L.; Gearry, Richard B.; Stedman, Catherine A. M. (October 2010). "Population-based epidemiology study of autoimmune hepatitis: a disease of older women?". Journal of Gastroenterology and Hepatology. 25 (10): 1681–1686. doi:10.1111/j.1440-1746.2010.06384.x. ISSN 1440-1746. PMID 20880179. S2CID 205466081.
- ↑ Primo, J.; Maroto, N.; Martínez, M.; Antón, M. D.; Zaragoza, A.; Giner, R.; Devesa, F.; Merino, C.; del Olmo, J. A. (October 2009). "Incidence of adult form of autoimmune hepatitis in Valencia (Spain)". Acta Gastro-Enterologica Belgica. 72 (4): 402–406. ISSN 1784-3227. PMID 20163033.
- 1 2 Grønbæk, Lisbet; Vilstrup, Hendrik; Jepsen, Peter (March 2014). "Autoimmune hepatitis in Denmark: incidence, prevalence, prognosis, and causes of death. A nationwide registry-based cohort study". Journal of Hepatology. 60 (3): 612–617. doi:10.1016/j.jhep.2013.10.020. ISSN 1600-0641. PMID 24326217.
- ↑ Aizawa Y, Hokari A (2017). "Autoimmune hepatitis: current challenges and future prospects". Clinical and Experimental Gastroenterology (Review). 10: 9–18. doi:10.2147/CEG.S101440. PMC 5261603. PMID 28176894.